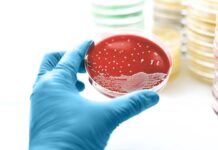
Pseudomonas aeruginosa: Огляд інфекції, ризики та профілактика

Гормональная терапия является краеугольным камнем лечения гормонально-позитивного метастатического рака молочной железы (МРМЖ), но часто сопровождается неприятными побочными эффектами. Эти методы лечения работают путем блокирования выработки или действия гормонов, что может нарушать нормальные функции организма и вызывать дискомфорт. Опыт варьируется в зависимости от конкретного используемого препарата, но распространенными проблемами являются сухость влагалища, приливы, боли в суставах, усталость и изменения либидо.
Хотя эти побочные эффекты могут быть пугающими, существует множество стратегий, которые могут облегчить состояние. Крайне важно обсудить любые новые подходы с вашей лечащей командой, чтобы убедиться, что они эффективно дополняют ваше противораковое лечение.
Облегчение боли в костях, суставах и мышцах
Ингибиторы ароматазы (например, анастрозол, экземестан и летрозол) и селективные деградаторы рецепторов эстрогена (SERD) часто вызывают боль в суставах и мышцах. Исследования показывают, что до 50% пациентов, принимающих ингибиторы ароматазы, испытывают эти симптомы, при этом до 25% прекращают лечение из-за боли.
К счастью, есть несколько методов, которые могут помочь:
- Мягкая растяжка: Регулярная, умеренная растяжка может противодействовать скованности, вызванной покоем. Начните медленно и переходите к упражнениям с низкой ударной нагрузкой, таким как тай-чи или водная терапия.
- Регулярная ходьба: Умеренная ходьба может уменьшить боль и скованность в суставах. Темпируйте себя и делайте перерывы, если боль усиливается.
- Тепло- и холодотерапия: Грелки или теплые ванны могут облегчить скованность, а холодные компрессы – уменьшить отек. Прикладывайте по 20 минут за раз.
- Противовоспалительная диета: Фрукты, овощи, цельнозерновые продукты и полезные жиры могут помочь уменьшить воспаление и боль в суставах.
- Обезболивающие препараты: Безрецептурные варианты, такие как ацетаминофен или ибупрофен, могут быть эффективны, но всегда сначала проконсультируйтесь со своим врачом.
- Акупунктура: Исследования показывают, что акупунктура может помочь улучшить боль и скованность в суставах.
Управление приливами и ночной потливостью
Гормональная терапия может резко снизить уровень эстрогена, вызывая приливы. До 86% пациентов сообщают о приливах после начала гормональной терапии. Распространенные методы лечения, вызывающие это, включают SERM (тамоксифен, торемифен), SERD (элацестрант, фулвестрант, имлунестрант) и ингибиторы ароматазы.
Для облегчения состояния:
- Избегайте алкоголя и кофеина: Они могут усугубить приливы.
- Выбирайте мягкие альтернативы: Отдавайте предпочтение менее острым продуктам и избегайте горячих напитков.
- Носите легкую одежду: Оставайтесь прохладными, нося дышащие ткани.
- Оставайтесь в помещении в жаркую погоду: Минимизируйте воздействие экстремальных температур.
- Обратитесь за поддержкой: Поговорите с другими женщинами об их стратегиях борьбы, таких как использование вентиляторов или многослойная одежда.
Снижение усталости и улучшение концентрации
Гормональная терапия иногда может вызывать усталость, туман в голове и когнитивные изменения. Хотя исследования продолжаются, эти проблемы могут быть связаны с побочными эффектами лечения или основными заболеваниями.
Чтобы справиться с усталостью и повысить концентрацию:
- Соблюдайте постоянный режим сна: Ложитесь спать и просыпайтесь в одно и то же время каждый день.
- Используйте календарь: Отслеживайте встречи и события, чтобы улучшить память.
- Минимизируйте отвлекающие факторы: Найдите тихое место, когда сосредотачиваетесь.
- Занимайтесь легкими физическими упражнениями: Ходьба или растяжка могут повысить уровень энергии. Исследования показывают, что под наблюдением проводимые упражнения улучшают качество жизни при распространенном раке молочной железы.
- Тренируйте свой мозг: Используйте приложения для тренировки мозга, головоломки или настольные игры, чтобы улучшить когнитивные функции.
Преодоление сексуальных побочных эффектов
Снижение уровня эстрогена во время гормональной терапии может вызывать сухость влагалища, боль во время секса (диспареунию) и снижение либидо. Некоторые исследования показывают, что сексуальная дисфункция увеличивается с 17,5% до лечения до 86% через шесть месяцев после начала.
Чтобы улучшить сексуальную функцию:
- Включите физические упражнения: Физическая активность может улучшить здоровье сердечно-сосудистой системы и настроение, косвенно улучшая сексуальную функцию.
- Обратитесь за консультацией: Специалист по психическому здоровью может помочь решить проблемы с интимностью.
- Используйте лубриканты: Негормональные, водорастворимые лубриканты могут облегчить сухость влагалища.
- Защищайте свои интересы: Не стесняйтесь обсуждать свои опасения со своим лечащим врачом для получения индивидуальных рекомендаций, включая направление к гинекологам или специалистам по тазовой физиотерапии.
Управление изменениями в теле
Гормональная терапия может привести к увеличению веса и накоплению жира. Хотя это не для всех является приоритетом, для некоторых это может быть неприятно. Небольшие изменения в диете и физических упражнениях могут иметь значение:
- Будьте активны: Адаптируйте свою программу упражнений к своим возможностям, например, совершайте ежедневные медленные прогулки.
- Проконсультируйтесь с диетологом: Получите рекомендации по здоровой, приятной диете.
- Обратитесь за поддержкой: Разговор со специалистами по психическому здоровью или группами поддержки может помочь справиться с изменениями в теле.
В заключение, гормональная терапия при МРМЖ может вызывать значительные побочные эффекты, но возможно активное управление. Комбинируя изменения образа жизни, медицинские вмешательства и открытое общение со своей лечащей командой, вы можете улучшить качество своей жизни во время лечения.
Источники:
Everyday Health следует строгим рекомендациям по отбору источников, чтобы обеспечить точность своего контента, как указано в нашей редакционной политике. Мы используем только надежные источники, включая рецензируемые исследования, сертифицированных врачей, пациентов с реальным опытом и информацию из ведущих учреждений.